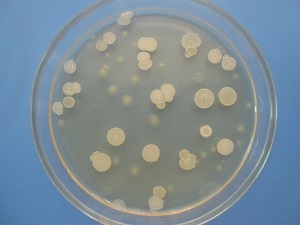

Цель исследования
- установить состояние микрофлоры влагалища;
- выявить половые инфекции и их патогены;
- определить уровень воспаления;
- оценить чистоту влагалища, что необходимо перед дальнейшими диагностическими исследованиями и гинекологическими процедурами, такими как прижигание эрозий, удаление полипов, выскабливание;
- проанализировать здоровье женщин во время беременности.
Мазок на флору у женщин является важной процедурой для оценки состояния микрофлоры влагалища. Врачи подчеркивают, что правильная подготовка к анализу, включая воздержание от половых контактов и использование вагинальных средств за 2-3 дня до сдачи, существенно влияет на точность результатов. Исследование позволяет выявить баланс между полезными и условно-патогенными микроорганизмами, что важно для диагностики различных заболеваний. Нормальные показатели микрофлоры включают наличие лактобактерий, которые обеспечивают защиту от инфекций. Врачи отмечают, что отклонения от нормы могут свидетельствовать о дисбактериозе или воспалительных процессах, что требует дальнейшего обследования и лечения. Регулярное проведение мазка помогает поддерживать женское здоровье и предотвращать осложнения.

Когда гинеколог берет мазок на флору?
- жалобы на зуд или выделения из влагалища, а также другие признаки воспаления;
- профилактические осмотры;
- контроль за лечением;
- использование гормональных препаратов и иммуносупрессоров;
- мониторинг микрофлоры при длительном применении антибиотиков;
- беременность. Исследование проводится трижды: при постановке на учет, на 30-й и 36-й неделях.
Это исследование известно как мазок на флору, общий мазок, бактериоскопия или мазок на чистоту. Также существуют мазки из мочеиспускательного канала и канала шейки матки. Обычно их берут одновременно.
Нормальная микрофлора влагалища
Влагалище здоровой женщины не стерильно. В нем обитают различные микроорганизмы, образующие микрофлору. Бактерии конкурируют за пространство на стенках влагалища и питательные вещества.
Наиболее распространены лактобактерии и бифидобактерии, которые прикрепляются к эпителию влагалища. Они вырабатывают спирты, перекись, молочную и другие кислоты, создавая кислую среду влагалищного секрета. Также они производят лизоцим и ферменты, сдерживающие размножение других бактерий.
Нарушение баланса микрофлоры влагалища
Микроорганизмы, входящие в состав микрофлоры здоровой женщины
| Микроорганизмы | Количество КОЕ/мл |
| Лактобактерии или палочки Додерлейна Lactobacillus spp | 10^7-10^9 |
| Бифидобактерии Bifidobacterium spp. | 10^3-10^7 |
| Клостридии Clostridium spp. | до 10^4 |
| Пропионибактерии Propionibacterium spp. | до 10^4 |
| Мобилункус Mobiluncus spp. | до 10^4 |
| Пептострептококки Peptostreptococcus spp | 10^3-10^4 |
| Коринебактерии Corynebacterium spp. | 10^4-10^5 |
| Стафилококки Staphylococcus spp. | 10^3-10^4 |
| Стрептококки Streptococcus spp. | 10^4-10^5 |
| Энтеробактерии Enterobacteriaceae | 10^3-10^4 |
| Бактероиды Bacteroides spp. | 10^3-10^4 |
| Превотеллы Prevotella spp. | до 10^4 |
| Порфиромонады Porphyromonas spp. | до 10^3 |
| Фузобактерии Fusobacterium spp. | до 10^3 |
| Вейлонеллы Veilonella spp. | до 10^3 |
| Микоплазмы M.hominis | до 10^3 |
| Уреаплазмы U.urealyticum | 10^3 |
| Кандиды — дрожжеподобные грибы | 10^4 |
КОЕ/мл обозначает колониеобразующие единицы в 1 мл питательной среды. Каждая единица представляет собой микроорганизм, из которого может образоваться колония.
Количество бактерий обычно выражается в десятичных логарифмах для удобства.
В описании влагалищной микрофлоры часто встречаются термины грамположительные и грамотрицательные бактерии. Первые окрашиваются по методу Грамма, вторые — нет.
Грамположительные палочки (лактобактерии) являются хорошим признаком. В норме они преобладают у женщин репродуктивного возраста. В период менопаузы и постменопаузы увеличивается количество грамотрицательных бактерий.
Бактерии делятся на:
- аэробные – развиваются при наличии кислорода;
- анаэробные – не требуют кислорода.
Во влагалище здоровой женщины большинство бактерий являются анаэробами с количеством 10^8–10^9 КОЕ/мл.
Как делают мазок на микрофлору влагалища?
Процедура взятия мазка осуществляется в кабинете гинеколога или в частной лаборатории.
Процесс включает несколько этапов:
- Женщина располагается в гинекологическом кресле.
- Вводятся стерильные гинекологические зеркала для доступа к стенкам влагалища и шейке матки.
- Сбор материала с задней стенки влагалища. Процедура безболезненна, неприятные ощущения могут возникнуть только при контакте шпателя с воспаленным участком.
- Нанесение материала на предметное стекло. Влагалищный секрет распределяется по стеклу тонким слоем.
- Фиксация мазка, если его доставляют в лабораторию более чем через 3 часа. Обработка предотвращает деформацию клеток.
- Окраска мазка по методу Грама с использованием метиленового синего для определения вида бактерий.
- Оценка результата, включая подсчет лейкоцитов, видовой состав микрофлоры и оценку чистоты влагалища.
Часто мазок берется из трех точек:
- отверстия мочеиспускательного канала и парауретральных ходов;
- стенок влагалища;
- канала шейки матки.
Для каждого участка используется отдельный стерильный инструмент. Мазок на флору из влагалища безопасен и разрешен даже беременным. Слизистая не травмируется, поэтому после процедуры нет ограничений.
Как подготовиться к мазку?
Сдавать мазок следует не ранее чем через 3 дня после окончания менструации, так как клетки менструальной крови могут исказить результаты. Оптимальный период — с 10-го по 20-й день цикла. Результат будет достовернее, если соблюдать следующие рекомендации:
- за 14 дней прекратить прием антибиотиков и противогрибковых средств;
- за 2 дня прекратить использование влагалищных препаратов;
- за 2-3 дня воздержаться от половых актов;
- перед процедурой не спринцеваться и не мыть внутри влагалища.
Что показывает мазок на микрофлору влагалища?
Мазок позволяет выявить ряд заболеваний и патологических состояний.
- Половые инфекции. Присутствие значительного количества уреаплазм, микоплазм, гарденелл, гонококков, трихомонад указывает на это.
- Воспаление влагалища (вагинит, кольпит) или канала шейки матки (цервицит). Признаком воспаления является повышенное количество лейкоцитов.
- Дисбактериоз влагалища. Изменение состава микрофлоры может привести к заболеваниям. Дисбактериоз диагностируется при снижении количества лактобактерий.
- Кандидоз. Нормально допустимо наличие единичных грибков рода Кандида. При грибковом поражении их количество резко увеличивается.
В мазке на флору оцениваются следующие показатели:
- Клетки плоского эпителия. В норме их количество единичное. Увеличение может указывать на воспаление. Отсутствие клеток говорит о атрофии слизистой.
- Лейкоциты. Превышение нормы (более 10 в поле зрения) может свидетельствовать о воспалении.
- Грамположительные палочки (лактобактерии). Снижение их количества указывает на дисбактериоз.
- Слизь. Увеличение слизи может указывать на воспаление в канале шейки матки.
- «Ключевые» клетки. Наличие этих клеток свидетельствует о влагалищном дисбактериозе.
- Спектр бактерий. Указываются виды бактерий, обнаруженные при микроскопическом исследовании. Палочковая флора считается нормой, коковая флора — тревожным признаком.
4 степени чистоты влагалища
| Степень | Выявленные изменения | О чем говорит |
| I | Среда кислая. Лейкоциты – до 10. Эпителиальные клетки – 5-10. Большинство микроорганизмов – лактобактерии. | Идеальное состояние микрофлоры. |
| II | Среда слабокислая. Лейкоциты – до 10. Эпителиальные клетки – 5-10. Большинство – палочки Додерлейна. | Нормальное состояние. |
| III | Среда нейтральная. Лейкоциты – свыше 10. Эпителиальные клетки – свыше 10. Присутствуют грамотрицательные и грамотрицательные палочки и кокки. | Воспаление влагалища – кольпит. |
| IV | Среда нейтральная или щелочная, рН свыше 4,5. Лейкоциты – свыше 30. Микроорганизмы в массивном количестве. | Выраженный воспалительный процесс. |
Какова норма мазка на микрофлору влагалища?
В микроскопии мазка на флору нормой считается:
- плоские клетки вагинального эпителия – до 10 в поле зрения;
- единичные лейкоциты – до 10 в поле зрения;
- клетки промежуточного слоя – единичные;
- «ложноключевые» клетки – редко;
- общее количество микроорганизмов «умеренное»;
- слизь – в небольшом количестве;
- среди бактерий преобладают лактобактерии.
В мазке не должно быть:
- Разрушенных клеток эпителия в большом количестве.
- Ключевых клеток.
- Парабазальных клеток.
- «Массивного» количества бактерий, кроме лактобактерий.
- Дрожжевых клеток с псевдомицелием.
- Строгих анаэробов.
- Гонококков.
- Трихомонад.
- Атипичных клеток.
Некоторые микроорганизмы (например, хламидии) не обнаруживаются при микроскопии. Для их выявления требуется анализ крови.
О чем говорят лейкоциты в мазке на флору влагалища?
Лейкоциты защищают организм от инфекций. Их количество не должно превышать 10. Увеличение указывает на воспаление.
Зачем производят чувствительность к антибиотикам при исследовании мазка?
Чувствительность к антибиотикам определяет, как бактерии реагируют на антибиотики. Исследование проводится при обнаружении патогенных бактерий.
Существует множество антибиотиков, но не все эффективны против всех бактерий. Иногда после курса антибиотиков пациентка не выздоравливает. Чтобы лечение было эффективным, необходимо определить, какие антибиотики:
- полностью уничтожают бактерию;
- останавливают рост возбудителя;
- не влияют на жизнедеятельность данной бактерии.
Составляется антибиотикограмма – список антибиотиков, к которым чувствительны бактерии.
Как происходит исследование на чувствительность к антибиотикам?
После определения бактерий их распределяют по пробиркам с питательными средами и добавляют антибиотики. Пробирки помещают в термостат на 7 дней.
После инкубации анализируют рост бактерий. В пробирках, где бактерии чувствительны к антибиотикам, колонии не образуются. В пробирках с нечувствительными бактериями рост будет интенсивным.
Что такое посев мазка?
Посев мазка – это лабораторное исследование, при котором содержимое влагалища помещается в питательную среду для роста бактерий.
Цели исследования:
- определить возбудителя инфекции половых органов;
- установить степень обсемененности;
- контролировать состояние микрофлоры после лечения антибиотиками.
В каких случаях назначают посев мазка?
- всем беременным при постановке на учет;
- при воспалительных процессах в половых органах;
- если в мазке обнаружены грамотрицательные диплококки;
- при рецидивирующем вульвовагините.
Как проводится микробиологическое исследование?
Отделяемое влагалища помещается в питательные среды. Пробирки помещаются в термостат на 3-5 дней.
После инкубации лаборант оценивает результаты. Из каждого микроорганизма вырастает колония. По ее внешнему виду определяется вид возбудителя, а по количеству колоний — концентрация микроорганизмов. Значимыми считаются бактерии с концентрацией более 10^4 КОЕ/мл.
В заключении, выдаваемом лабораторией, указывается:
- вид микроорганизма;
- патогенность микроорганизма;
- концентрация микроорганизма во влагалище.
Количество и рост бактерий может характеризоваться степенью:
| Степень | Особенности роста бактерий | |
| Жидкая питательная среда | Плотная питательная среда | |
| I | Рост очень скудный. | Рост отсутствует. |
| II | Умеренный рост | До 10 колоний. |
| III | Обильный рост. | От 10 до 100 колоний. |
| IV | Массивный рост. | Свыше 100 колоний. |
I степень является нормой. II степень указывает на нарушение микрофлоры. III-IV степени свидетельствуют о заболевании.
| Аспект исследования | Подробное описание | Нормальные показатели / Рекомендации |
|---|---|---|
| Зачем производят мазок на флору? | Диагностика воспалительных заболеваний влагалища и шейки матки (вагинит, кольпит, цервицит), выявление инфекций, передающихся половым путем (ИППП), оценка состояния микрофлоры влагалища, контроль эффективности лечения. | Профилактическое обследование рекомендуется 1-2 раза в год, а также при наличии симптомов (зуд, жжение, выделения, боль). |
| Подготовка к исследованию | За 2-3 дня до анализа исключить половые контакты, спринцевание, использование вагинальных свечей, кремов и тампонов. Желательно проводить исследование не во время менструации (лучше через 3-5 дней после окончания). Утром перед забором материала следует подмыться чистой водой без мыла. | Подробные инструкции предоставит врач или медицинская сестра. |
| Расшифровка результатов: Лейкоциты | Клетки иммунной системы, повышение их количества указывает на воспалительный процесс. | Норма: до 10-15 в поле зрения. Повышение – признак воспаления. |
| Расшифровка результатов: Эпителиальные клетки | Клетки слизистой оболочки влагалища. Их количество может меняться в зависимости от фазы менструального цикла. | Норма: умеренное количество. Значительное увеличение может указывать на атрофические процессы или воспаление. |
| Расшифровка результатов: Микрофлора | Определение типа и количества микроорганизмов во влагалище. В норме преобладает лактобациллярная флора (палочки Додерлейна). | Норма: преобладание лактобацилл, отсутствие патогенной микрофлоры (гарднерелл, гонококков, хламидий, трихомонад, грибов рода Candida и др.). Наличие других микроорганизмов указывает на дисбиоз или инфекцию. |
| Расшифровка результатов: pH влагалища | Показатель кислотности влагалищной среды. | Норма: 3,8-4,5. Повышение pH может указывать на бактериальный вагиноз или другие инфекции. |
| Дополнительные исследования | При обнаружении отклонений от нормы могут быть назначены дополнительные исследования: посев на флору с определением чувствительности к антибиотикам, ПЦР-диагностика на ИППП. | Врач назначит необходимые дополнительные анализы в зависимости от результатов мазка. |
Мазок на флору у женщин — это важный анализ, который позволяет оценить состояние микрофлоры влагалища и выявить возможные инфекции или дисбаланс. Подготовка к исследованию включает воздержание от половых контактов, использования вагинальных средств и спринцеваний за 2-3 дня до процедуры. Результаты мазка расшифровываются на основе наличия различных микроорганизмов: лактобактерий, кокков, грибов и других. Нормальные показатели свидетельствуют о здоровой микрофлоре, где преобладают лактобактерии, обеспечивающие защиту от патогенных бактерий. Отклонения могут указывать на воспалительные процессы или инфекции, что требует дальнейшего обследования и лечения. Регулярное проведение этого анализа помогает поддерживать женское здоровье и предотвращать осложнения.

Нормальная микрофлора влагалища
Влагалище здоровой женщины не стерильно. В нем обитает множество микроорганизмов, формирующих микрофлору. Бактерии конкурируют за места на стенках влагалища и доступ к питательным веществам.
Наиболее распространены лактобактерии и бифидобактерии, прикрепляющиеся к эпителию влагалища. Эти микроорганизмы производят спирты, перекись водорода, молочную и другие кислоты, создавая кислую среду влагалищного секрета. Они также вырабатывают лизоцим и другие ферменты, контролирующие рост других бактерий.
Нарушение баланса микрофлоры влагалища

Микроорганизмы, входящие в состав микрофлоры здоровой женщины
| Микроорганизмы | Количество КОЕ/мл |
| Лактобактерии или палочки Додерлейна Lactobacillus spp | 107-109 |
| Бифидобактерии Bifidobacterium spp. | 103-107 |
| Клостридии Clostridium spp. | До 104 |
| Пропионибактерии Propionibacterium spp. | До 104 |
| Мобилункус Mobiluncus spp. | До 104 |
| Пептострептококки Peptostreptococcus spp | 103-104 |
| Коринебактерии Corynebacterium spp. | 104-105 |
| Стафилококки Staphylococcus spp. | 103-104 |
| Стрептококки Streptococcus spp. | 104-105 |
| Энтеробактерии Enterobacteriaceae | 103-104 |
| Бактероиды Bacteroides spp. | 103-104 |
| Превотеллы Prevotella spp. | До 104 |
| Порфиромонады Porphyromonas spp. | До 103 |
| Фузобактерии Fusobacterium spp. | До 103 |
| Вейлонеллы Veilonella spp. | До 103 |
| Микоплазмы M.hominis | До 103 |
| Уреаплазмы U.urealyticum | 103 |
| Кандиды — дрожжеподобные грибы | 104 |
КОЕ/мл обозначает количество колониеобразующих единиц в одном миллилитре питательной среды. Каждая единица представляет собой микроорганизм, способный образовать колонию.
Количество бактерий указывается в десятичных логарифмах для удобства.
В описании микрофлоры влагалища часто встречаются термины грамположительные и грамотрицательные бактерии. Первые окрашиваются по методу Грамма, вторые — нет.
Грамположительные палочки в мазке, такие как лактобактерии, являются положительным признаком. В норме они преобладают у женщин репродуктивного возраста, в то время как в период менопаузы и постменопаузы увеличивается количество грамотрицательных бактерий.
Бактерии делятся на:
- аэробные – развиваются при наличии кислорода;
- анаэробные – не требуют кислорода.
Во влагалище здоровой женщины большинство бактерий – анаэробы, с количеством 108–109 КОЕ/мл.
Как делают мазок на микрофлору влагалища?
Процедура взятия мазка проводится в кабинете гинеколога или частной лаборатории.
Исследование включает несколько этапов:
- Женщина располагается в гинекологическом кресле.
- Вводятся стерильные гинекологические зеркала для доступа к стенкам влагалища и шейке матки.
- Материал собирается с задней стенки влагалища. Процедура безболезненна, возможен незначительный дискомфорт при контакте шпателя с воспалённой областью.
- Собранный материал наносится на предметное стекло. Влагалищный секрет распределяется тонким слоем, чтобы клетки не перекрывали друг друга.
- Фиксация мазка необходима, если он будет доставлен в лабораторию более чем через три часа. Это предотвращает деформацию клеток при высыхании.
- Окрашивание мазка по методу Грама с использованием метиленового синего. Это упрощает определение вида бактерий и состава микрофлоры.
- Оценка результатов включает подсчет лейкоцитов, видовой состав микрофлоры и оценку чистоты влагалища.
Мазок часто берется из трех зон:
- отверстия мочеиспускательного канала и парауретральных ходов;
- стенок влагалища;
- канала шейки матки.
Анатомическая близость этих областей позволяет инфекциям и воспалениям взаимно влиять друг на друга. Для каждого участка используется отдельный стерильный шпатель, щеточка или ватный тампон. Собранный материал наносится на три стерильных предметных стекла.
Мазок на флору из влагалища безопасен и разрешен для беременных. Слизистая не повреждается, поэтому после процедуры нет ограничений: можно принимать ванну, плавать, заниматься сексом и т.д.
Как подготовиться к этому мазку?
Сдавать мазок на флору следует не ранее чем через три дня после менструации, так как клетки менструальной крови могут исказить результаты. Оптимальный период для анализа — с 10-го по 20-й день менструального цикла.
Для достоверных результатов соблюдайте следующие рекомендации:
- За 14 дней до анализа прекратите прием антибиотиков и противогрибковых средств.
- За два дня до процедуры откажитесь от влагалищных препаратов: растворов, свечей, таблеток, тампонов, мазей и кремов.
- За 2-3 дня воздержитесь от половых контактов.
- Не проводите спринцевание и не мойте влагалище изнутри перед сдачей анализа.
Что показывает мазок на микрофлору влагалища?
Мазок на микрофлору влагалища помогает выявить заболевания и патологические состояния.
- Половые инфекции. Большое количество уреаплазм, микоплазм, гарденелл, гонококков, трихомонад и других патогенных бактерий указывает на наличие половых инфекций.
- Воспаление влагалища (вагинит, кольпит) или шейки матки (цервицит, эндоцервицит). Повышенное количество лейкоцитов в мазке свидетельствует о воспалительном процессе.
- Дисбактериоз влагалища. Изменение состава микрофлоры может привести к заболеваниям половой системы. Дисбактериоз диагностируется при снижении лактобактерий и увеличении других микроорганизмов.
- Кандидоз. В норме в мазке могут встречаться единичные грибки рода Кандида. При грибковой инфекции их количество возрастает, и в мазке можно обнаружить псевдомицелий – нити удлиненных клеток и клетки-почки.
В мазке на флору анализируются следующие показатели:
- Клетки плоского эпителия. В норме их количество невелико. Увеличение может указывать на воспаление (вагинит, цервицит). Полное отсутствие клеток может свидетельствовать о атрофии слизистой из-за нехватки женских половых гормонов. Количество плоского эпителия изменяется в разные фазы менструального цикла.
- Лейкоциты. Превышение нормы (более 10 в поле зрения) указывает на воспалительный процесс. Чем больше лейкоцитов, тем сильнее воспаление.
- Грамположительные палочки – лактобактерии. Эти микроорганизмы составляют основу здоровой влагалищной флоры, питаются гликогеном и производят молочную кислоту, подавляющую рост других бактерий. Снижение лактобацилл указывает на дисбактериоз и часто сопровождает инфекции половых органов.
- Слизь. Секрет, вырабатываемый железами шейки матки. В норме количество выделяемой и впитываемой слизи примерно одинаково. Увеличение (более 5 мл в сутки) может свидетельствовать о воспалении в шейке матки.
- «Ключевые» клетки – клетки плоского эпителия, окруженные бактериями, преимущественно гарденеллами. Наличие таких клеток указывает на влагалищный дисбактериоз.
- Спектр бактерий. Указываются виды бактерий, выявленные при микроскопическом исследовании мазка. Палочковая флора считается нормой, так как лактобактерии имеют форму палочек. Коковая флора указывает на преобладание стрептококков или стафилококков. Смешанная флора говорит о наличии как палочковидных, так и кокковых микроорганизмов, что может наблюдаться при бактериальном вагинозе.
4 степени чистоты влагалища
| Степень | Выявленные изменения | О чем говорит |
| I | Кислая среда. Лейкоциты – до 10. Эпителиальные клетки – 5-10. Преобладают лактобактерии. Другие бактерии – в единичных количествах. Слизь – в небольшом объеме. | Оптимальная микрофлора влагалища. Редко встречается у женщин репродуктивного возраста с активной половой жизнью. |
| II | Слабокислая среда. Лейкоциты – до 10. Эпителиальные клетки – 5-10. Основные – палочки Дедерлейна. Небольшое количество грамположительных кокков. Слизь – в небольшом количестве. | Нормальное состояние, характерное для большинства здоровых женщин. |
| III | Нейтральная среда. Лейкоциты – более 10. Эпителиальные клетки – более 10. Микроорганизмы в умеренном или большом количестве. Обнаруживаются грамотрицательные и грамположительные палочки и кокки. Единичные палочки Дедерлейна. Присутствуют «ключевые» клетки. Слизь – в умеренном объеме. | Воспаление влагалища – кольпит. Возможны кремообразные выделения, зуд, жжение, дискомфорт при половом акте. У некоторых женщин симптомы могут отсутствовать. |
| IV | Нейтральная или щелочная среда, рН выше 4,5. Лейкоциты – более 30 или все поле зрения. Эпителиальные клетки – в большом количестве. Микроорганизмы – в массивном количестве. Микрофлора включает условно-патогенные и патогенные микроорганизмы. Палочки Дедерлейна могут отсутствовать. Слизь – в большом объеме. | Ярко выраженное воспаление. Симптомы: обильные выделения (белые, желтоватые, зеленоватые) с неприятным запахом, зуд, жжение, дискомфорт. Неприятные ощущения и боль при половом акте. |
Какова норма мазка на микрофлору влагалища?
В микроскопическом исследовании мазка на флору нормальные показатели:
- плоские клетки вагинального эпителия – до 10 в поле зрения;
- единичные лейкоциты – до 10 в поле зрения;
- клетки промежуточного слоя – в единичном количестве;
- «ложноключевые» клетки – редко;
- общее количество микроорганизмов – «умеренное» или «большое»;
- слизь – в небольшом объеме;
- преобладание лактобактерий, другие микроорганизмы встречаются редко.
В мазке не должно быть:
- Большого количества разрушенных клеток эпителия. Это может указывать на лизис клеток из-за увеличения лактобактерий.
- Ключевых клеток. Это эпителиальные клетки, покрытые бактериями.
- Парабазальных клеток. Эти клетки нижних слоев слизистой указывают на воспаление или атрофию.
- «Массированного» количества бактерий, кроме лактобактерий.
- Дрожжевых клеток с псевдомицелием и бластопорами. Их наличие свидетельствует о молочнице.
- Строгих анаэробов, большинство из которых вызывают заболевания.
- Гонококков, вызывающих гонорею.
- Трихомонад, являющихся возбудителями трихомониаза.
- Атипичных клеток, которые могут указывать на предраковые или онкологические изменения.
Некоторые микроорганизмы, такие как хламидии и вирусы, не видны при микроскопии из-за небольшого размера. Для их обнаружения требуется анализ крови на РПЦ.
О чем говорят лейкоциты в мазке на флору влагалища?
Лейкоциты – белые кровяные клетки, которые защищают организм от инфекций. Они могут проходить через стенки сосудов и перемещаться самостоятельно. Лейкоциты обладают способностью к фагоцитозу, что позволяет им поглощать и переваривать бактерии. После этого лейкоцит погибает, высвобождая вещества, вызывающие воспаление, проявляющееся отеком и покраснением слизистой оболочки.
В норме количество лейкоцитов во влагалище не должно превышать 10. Их увеличение указывает на воспалительный процесс: чем больше лейкоцитов, тем ярче симптомы воспаления.
Зачем производят чувствительность к антибиотикам при исследовании мазка?
Чувствительность к антибиотикам или антибиотикограмма – это процесс определения реакции бактерий на антибиотики. Исследование проводится одновременно с посевом мазка, когда в влагалище обнаруживаются патогенные микроорганизмы, вызывающие воспалительные процессы или инфекции, передающиеся половым путем.
Эффективность антибиотиков варьируется в зависимости от групп бактерий (антибиотики не действуют на вирусы). Иногда после курса антибиотиков пациентка не ощущает улучшений или болезнь возвращается через несколько дней или недель. Это может быть связано с назначением антибиотиков, неэффективных против конкретного возбудителя инфекции.
Для эффективного лечения необходимо выяснить, какие антибиотики:
- полностью уничтожают бактерию — возбудителя инфекции;
- замедляют её рост;
- не влияют на жизнедеятельность данной бактерии.
На основе исследования формируется антибиотикограмма — список антибиотиков, к которым проявляют чувствительность выявленные бактерии.
Как происходит исследование на чувствительность к антибиотикам?
После выявления бактерий, вызывающих заболевание, их распределяют по пробиркам с питательными средами, добавляя в каждую определенный антибиотик. Пробирки помещают в термостат для оптимальных условий размножения.
Через 7 дней анализируют рост бактерий. В пробирках, где бактерии чувствительны к антибиотикам, колонии не образуются. Этот препарат подходит для лечения пациентки. В пробирке с антибиотиками, к которым бактерии устойчивы, наблюдается активный рост. Эти медикаменты не подходят для терапии заболевания.
Что такое посев мазка?
Посев мазка или бактериологический посев мазка – лабораторное исследование, при котором содержимое влагалища помещается в питательную среду для роста бактерий.
Цели исследования:
- выявление возбудителя инфекции половых органов;
- определение уровня обсемененности – количества бактерий во влагалище;
- контроль состояния микрофлоры после длительного применения антибиотиков и цитостатиков. Исследование проводят через 7-10 дней после прекращения приема препарата.
Когда назначают посев мазка?
- всем беременным женщинам при регистрации;
- при воспалительных процессах в половых органах;
- если в мазке обнаружены грамотрицательные диплококки – для подтверждения гонококковой инфекции (гонореи);
- при рецидивирующем или хроническом вульвовагините.
Как проводится микробиологическое исследование?
Отделяемое влагалища помещается в питательные среды – растворы или желеобразные массы, содержащие вещества для роста бактерий. Пробирки и чашки Петри помещаются в термостат на 3-5 дней при температуре около 37 градусов, что оптимально для размножения микроорганизмов.
После культивации лаборант анализирует результаты. Из каждой бактерии образуется колония. По внешнему виду колонии определяется вид возбудителя, а по количеству колоний оценивается концентрация микроорганизмов во влагалище. Полученные данные сравниваются с нормальными показателями. Значимым считается наличие бактерий с концентрацией более 10^4 КОЭ/мл, что может вызвать заболевание. Если обнаруживается такое количество бактерий, результат анализа считается положительным.
В заключении, выданном лабораторией, указывается:
- вид преобладающего микроорганизма в мазке;
- патогенность микроорганизма – его способность вызывать заболевание:
- Патогенный – присутствие связано только с болезнью.
- Условно-патогенный – бактерии, способные вызывать заболевание при снижении иммунитета или увеличении численности.
- концентрация микроорганизма во влагалище, представленная в числовом значении и в виде словесной характеристики: «скудно», «умеренный рост», «обильный рост».
В лабораторном заключении количество и рост бактерий характеризуются по степени:
| Степень | Особенности роста бактерий | |
| Жидкая питательная среда | Плотная питательная среда | |
| I | Рост очень скудный. | Рост отсутствует. |
| II | Умеренный рост. | До 10 колоний. |
| III | Обильный рост. | От 10 до 100 колоний. |
| IV | Массивный рост. | Свыше 100 колоний. |
I степень считается нормой. II степень указывает на нарушение микрофлоры влагалища, III-IV степени свидетельствуют о наличии заболевания, вызванного определенными бактериями.
Вопрос-ответ
Каковы причины плохого мазка на флору?
Причины «плохого» мазка – кандидозный вульвовагинит, или попросту «молочница», – трихомонадный кольпит – воспалительный процесс, вызванный трихомонадами, которые передаются половым путем.
Что в мазке на флору говорит о воспалении?
В мазке на флору специалист смотрит на количество клеток эпителия. Превышение нормы свидетельствует о воспалении или избытке гормона эстрадиола, который стимулирует рост и деление клеток эпителия. Заниженное их количество говорит об избытке андрогенов, нехватке эстрадиола или об атрофических изменениях.
О чем говорит хороший мазок на флору?
Мазок на флору позволяет оценить состав микрофлоры влагалища, а также выявить возможные отклонения от нормы. В нормальном состоянии микрофлора женщины должна содержать большое количество полезных бактерий, в первую очередь лактобактерий и бифидобактерий.
Советы
СОВЕТ №1
Перед проведением мазка на флору, избегайте использования вагинальных средств, таких как гели, свечи или спреи, за 2-3 дня до процедуры. Это поможет получить более точные результаты анализа.
СОВЕТ №2
Лучшее время для сдачи мазка — это период, когда у вас нет менструации. Это обеспечит чистоту образца и снизит вероятность искажения результатов.
СОВЕТ №3
Обязательно сообщите врачу о любых симптомах, таких как зуд, жжение или необычные выделения, так как это может повлиять на интерпретацию результатов анализа.
СОВЕТ №4
После получения результатов мазка, не стесняйтесь задавать вопросы врачу. Понимание нормальных показателей микрофлоры влагалища поможет вам лучше заботиться о своем здоровье.